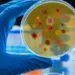
Rajouri mysterious disease, Badal village deaths, GMC Rajouri, Jammu Kashmir health crisis, containment zone Rajouri, Union Home Ministry investigation, forensic team Chandigarh, neurological damage disease, Rajouri health news, mysterious illness in Jammu, toxic elements in Rajouri, Rajouri disease death toll, Omar Abdullah statement, Kotranka health crisis.

जम्मू (Jammu) 23 जनवरी (The News Air): भारत के खूबसूरत कश्मीर (Kashmir) घाटी को वंदे भारत एक्सप्रेस (Vande Bharat Express) से जोड़ने की ऐतिहासिक पहल शुरू हो चुकी है। रेलवे की उधमपुर-श्रीनगर-बारामूला रेल लिंक परियोजना (Udhampur-Srinagar-Baramulla Rail Link Project) के तहत श्री माता वैष्णो देवी कटड़ा (Katra Railway Station) से बड़गाम (Budgam Railway Station) के बीच वंदे भारत ट्रेन का ट्रायल 24 और 25 जनवरी को होने जा रहा है।
उत्तर रेलवे (Northern Railway) के अनुसार, इस परियोजना का उद्घाटन फरवरी के पहले सप्ताह में होने की संभावना है। इस संबंध में रेलवे अधिकारियों ने संबंधित तैयारियों को तेज करने के निर्देश दिए हैं।
वंदे भारत का ट्रायल: ऐतिहासिक कनेक्टिविटी का पहला कदम
रेलवे के उच्चाधिकारियों ने इस ट्रायल को बेहद अहम बताया है। रेलवे सूत्रों के अनुसार, सकूर बस्ती (Sakoor Basti) में खासतौर पर वंदे भारत ट्रेनों को तैयार किया गया है। ये दोनों रैक जल्द ही श्री माता वैष्णो देवी कटड़ा रेलवे स्टेशन पर पहुंचाए जाएंगे।
- 24 और 25 जनवरी को ट्रायल:
इन दोनों दिनों में कटड़ा रेलवे स्टेशन (Katra Railway Station) से बड़गाम रेलवे स्टेशन (Budgam Railway Station) तक वंदे भारत का ट्रायल किया जाएगा। - यात्रियों की सुविधा में वृद्धि:
यह ट्रेन यात्रा समय को कम करेगी और कश्मीर को बाकी भारत से और मजबूत तरीके से जोड़ेगी।
प्रोजेक्ट की समीक्षा में जुटे रेलवे अधिकारी
प्रिंसिपल एग्जीक्यूटिव डायरेक्टर गति शक्ति रेलवे बोर्ड (Principal Executive Director Gati Shakti Railway Board), एन.सी. कारमाली (N.C. Karmali) ने श्रीनगर पहुंचकर परियोजना का निरीक्षण किया।
- उन्होंने श्रीनगर से कटड़ा रेलवे ट्रैक (Srinagar to Katra Railway Track) की स्थिति का जायजा लिया।
- चिनाब ब्रिज (Chenab Bridge) और अंजी ब्रिज (Anji Bridge) साइट पर जाकर प्रगति का निरीक्षण किया।
- बुधवार देर शाम उन्होंने कटड़ा स्टेशन पर वापस पहुंचकर तैयारियों की जानकारी ली।
परियोजना के फायदे और संभावनाएं
उधमपुर-श्रीनगर-बारामूला रेल लिंक परियोजना को भारत की सबसे चुनौतीपूर्ण और महत्वाकांक्षी रेल परियोजनाओं में से एक माना जाता है।
- कश्मीर को जोड़ने वाला महत्वपूर्ण लिंक: यह परियोजना जम्मू और कश्मीर के पर्यटन (Tourism in Kashmir) और व्यापार (Trade) के लिए मील का पत्थर साबित होगी।
- वंदे भारत ट्रेन की आधुनिकता: वंदे भारत एक्सप्रेस की गति, सुविधाएं और यात्रियों के लिए आरामदायक अनुभव इसे खास बनाएंगे।
- चिनाब ब्रिज: दुनिया का सबसे ऊंचा रेलवे ब्रिज, चिनाब ब्रिज, इस परियोजना का हिस्सा है और यह इंजीनियरिंग का उत्कृष्ट नमूना है।
फरवरी में उद्घाटन की तैयारी
रेलवे के अधिकारियों के अनुसार, परियोजना का उद्घाटन फरवरी के पहले सप्ताह में संभावित है। इसके बाद वंदे भारत ट्रेन को कश्मीर की वादियों में नियमित रूप से चलाया जाएगा।
- उद्घाटन के लिए प्रधानमंत्री नरेंद्र मोदी (PM Narendra Modi) या रेल मंत्री अश्विनी वैष्णव (Ashwini Vaishnaw) के शामिल होने की संभावना है।
- यह उद्घाटन कश्मीर की कनेक्टिविटी में एक नया युग शुरू करेगा।
वंदे भारत एक्सप्रेस का कश्मीर घाटी में ट्रायल और परियोजना का उद्घाटन भारत के रेलवे इतिहास का ऐतिहासिक क्षण होगा। यह पहल न केवल कश्मीर के पर्यटन को बढ़ावा देगी, बल्कि क्षेत्रीय विकास और व्यापार के नए रास्ते भी खोलेगी। भारतीय रेलवे के इस कदम से यात्रियों को तेजी, सुविधा और विश्व स्तरीय अनुभव का लाभ मिलेगा। कश्मीर घाटी अब वंदे भारत के जरिए देश के बाकी हिस्सों से और करीब जुड़ने जा रही है।
ताज़ा खबरों के लिए हमसे जुड़ें